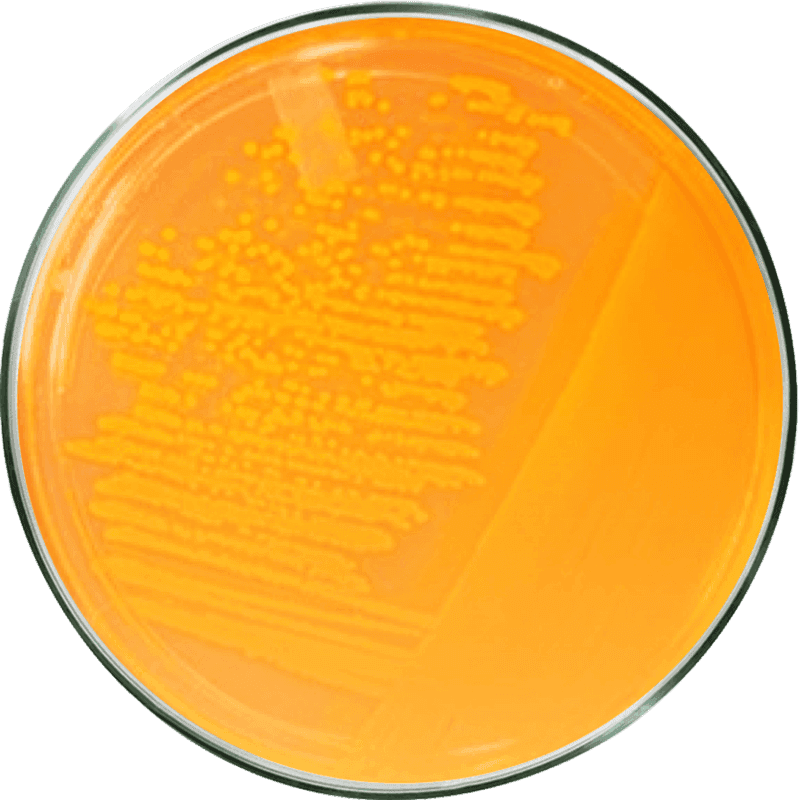

Probiotika
Klinisch geprüfte Präbiotika, Probiotika und Enzyme zur Unterstützung der täglichen Verdauung und des allgemeinen Wohlbefindens.


Inhaltsstoffe
Alle Zutaten wurden sorgfältig aufgrund ihrer nachgewiesenen Wirksamkeit ausgewählt und in höchster Qualität bezogen.

Ein probiotischer Bakterienstamm, der die Darmgesundheit fördert und das Gleichgewicht der Darmflora unterstützt.

Eine patentierte Mischung aus fünf ausgewählten Enzymen, die die Verdauung von Stärke, Proteinen, Fetten, Zellulose und Laktose unterstützen.

Enthält Actinidain, ein einzigartiges proteolytisches Enzym aus der Kiwifrucht, das die Verdauung verbessert und Blähungen sowie Unwohlsein reduziert.
Unterstützen die Darmbewegung und helfen, den Stuhlgang zu regulieren und tragen zur allgemeinen Darmgesundheit bei.
Actazin® ist eine eingetragene Marke der Anagenix IP Limited. DigeZyme® ist eine eingetragene Marke der Sabinsa Corporation / Sabinsa Europe GmbH.
Probiotika ≠ Probiotika
Liefert dir jeden Tag wichtige Darmbakterien, Mineralstoffe, Antioxidantien, Vitamine, natürliche Pflanzenstoffe und mehr.
Gängige Probiotika | Synbiotika-Produkte | Multivitamin-Präparate | ||
|---|---|---|---|---|
Bakterienkulturen | ||||
Präbiotische Ballaststoffe |
Pflanzenextrakte |
Vitamine & Mineralstoffe |
Zucker / Süßungsmittel |
Basierend auf einer Auswahl an Produkten auf dem Markt für Nahrungsergänzungsmittel.
Neu
Verdauungsenzyme und lebende Bakterien
Neu
Verdauungsenzyme und lebende Bakterien
Sorgfältig ausgewählte Prä- und Probiotika mit natürlichen Verdauungsenzymen, um deine Darmflora zu unterstützen und die Nährstoffaufnahme zu optimieren. Dieses Synbiotikum fördert ein ausgewogenes Mikrobiom und trägt zu mehr Wohlbefinden im Alltag bei – sanft, wirkungsvoll und ideal für den täglichen Gebrauch.